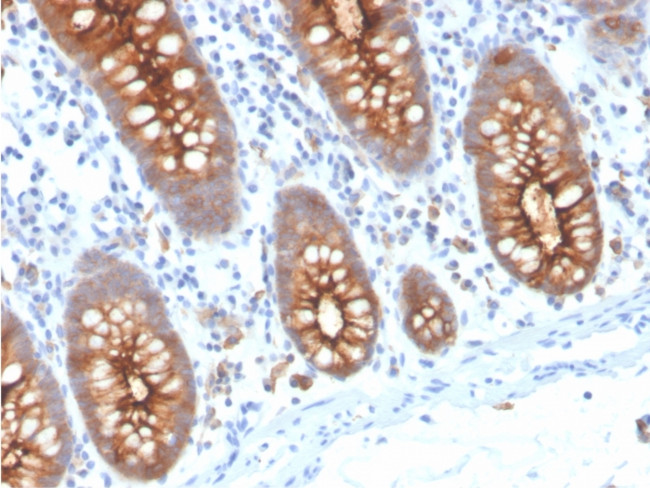
Carcinoembryonic Antigen (CEA)/CD66e Antibody in Immunohistochemistry (Paraffin) (IHC (P))

Search
NeoBiotechnologies
Carcinoembryonic Antigen (CEA)/CD66e Recombinant Rabbit Monoclonal Antibody (C66/3707R)
{{$productOrderCtrl.translations['antibody.pdp.commerceCard.promotion.promotions']}}
{{$productOrderCtrl.translations['antibody.pdp.commerceCard.promotion.viewpromo']}}
{{$productOrderCtrl.translations['antibody.pdp.commerceCard.promotion.promocode']}}: {{promo.promoCode}} {{promo.promoTitle}} {{promo.promoDescription}}. {{$productOrderCtrl.translations['antibody.pdp.commerceCard.promotion.learnmore']}}
产品信息
1048-RBM17-P1ABX
种属反应
宿主/亚型
Expression System
分类
类型
克隆号
抗原
偶联物
形式
浓度
纯化类型
保存液
内含物
保存条件
运输条件
靶标信息
CEA (Carcino Embryonic Antigen, CD66e) is synthesized during development in the fetal gut, and re-expressed in increased amounts in intestinal carcinomas and several other tumors. CEA is a member of carcinoembryonic antigens, immunoglobulin supergene family and consists of a single N domain (structural homology to the immunoglobulin variable) and six immunoglobulin constant-like A (A1, A2, A3) and B domains (B1, B2, B3). Antibodies to CEA are useful in identifying the origin of various metastatic adenocarcinomas and in distinguishing pulmonary adenocarcinomas (60 to 70% are CEA+) from pleural mesotheliomas (rarely or weakly CEA+). CEA is a member of a large family of glycoproteins, a useful tumor marker for adenocarcinoma, and found in adenocarcinomas of endodermally derived digestive system epithelium and fetal colon. Two subgroups of the CEA family, the CEA cell adhesion molecules and the pregnancy-specific glycoproteins, are located within a 1.2 Mb cluster on the long arm of chromosome 19. Eleven pseudogenes of the CEA cell adhesion molecule subgroup are also found in the cluster. CEA was originally described in bile ducts of liver as biliary glycoprotein. Subsequently, CEA was found to be a cell-cell adhesion molecule detected on leukocytes, epithelia, and endothelia. The encoded protein mediates cell adhesion via homophilic as well as heterophilic binding to other proteins of the subgroup. Multiple cellular activities have been attributed to the encoded protein, including roles in the differentiation and arrangement of tissue three-dimensional structure, angiogenesis, apoptosis, tumor suppression, metastasis, and the modulation of innate and adaptive immune responses. Multiple transcript variants encoding different isoforms have been reported, but the full-length nature of all variants has not been defined.
仅用于科研。不用于诊断过程。未经明确授权不得转售。
篇参考文献 (0)
生物信息学
蛋白别名: Carcinoembryonic antigen; Carcinoembryonic antigen-related cell adhesion molecule 5; CD66e; CEA; CEA cell adhesion molecule 5; Cell adhesion molecule CEACAM5; Meconium antigen 100; OTTHUMP00000199033; sCD66e; soluble CD66e
基因别名: CD66e; CEA; CEACAM5
UniProt ID: (Human) P06731
Entrez Gene ID: (Human) 1048